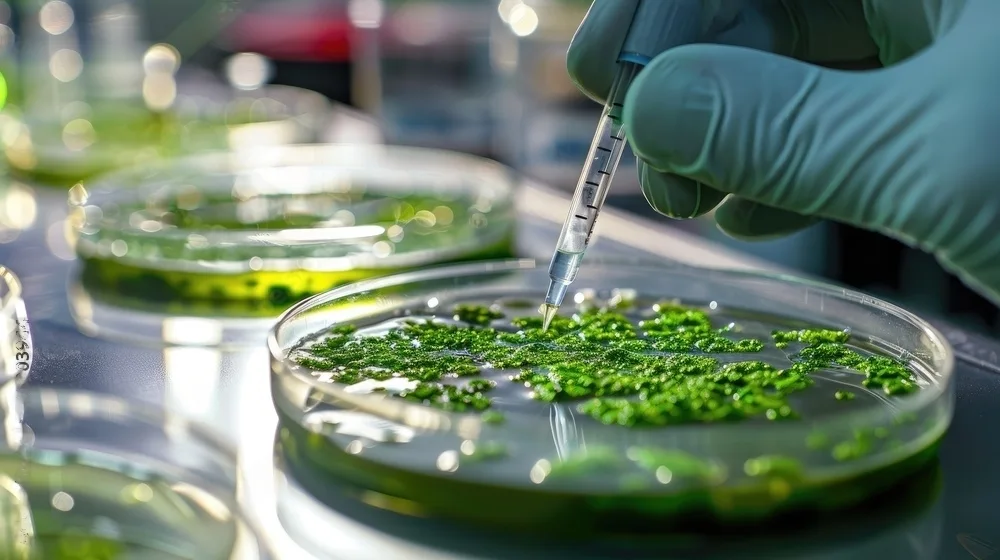

Innovations

Future through Biotechnology
At Lafiny Greentech, innovation is ingrained in our DNA. We are dedicated to pushing the boundaries of biotechnology to develop transformative solutions that address global challenges and drive positive change. Our commitment to innovation drives every aspect of our operations, from research and development to commercialization.
Our Innovation Mission
Our mission is to leverage the power of biotechnology to pioneer groundbreaking innovations that make a meaningful impact on society and the environment.
Push Technological Frontiers
We invest in cutting edge research and development to explore new technologies and unlock novel applications of biotechnology.
Solve Complex Problems
We tackle complex challenges, from sustainable agriculture to healthcare, by developing innovative solutions that deliver tangible benefits.
Embrace Cross-Disciplinary Collaboration
We foster collaboration across scientific disciplines and industries to spark creativity and accelerate innovation.

Innovation Initiatives

Research Excellence
Research excellence is paramount. Our scientists and engineers are engaged in innovative projects that span biopharmaceuticals, renewable energy, agricultural biotechnology, and more. We prioritize curiosity-driven research that leads to breakthrough discoveries.

Technology Incubation
We incubate and nurture new technologies with the potential for real-world impact. From proof-of-concept studies to pilot-scale demonstrations, we support the development of innovative ideas into viable products and solutions.

Startup Acceleration
Aagmam supports entrepreneurship and innovation through startup acceleration programs. We collaborate with emerging ventures to provide mentorship, funding, and access to resources that catalyze innovation in biotechnology.
Innovation Metrics
To measure our impact and drive continuous improvement, we track key innovation metrics, including:
- Number of patents filed and granted
- Success rate of research and development projects
- Collaborations with academic institutions and industry partners
- Commercialization of new products and technologies


get in touch
For inquiries about our sustainability practices or to explore potential collaborations, please contact us.
